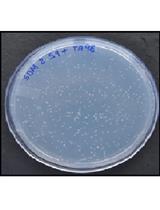
Microbial Mutagenicity Assay: Ames Test

- Submit a Protocol
- Receive Our Alerts
- Log in
- /
- Sign up
- My Bio Page
- Edit My Profile
- Change Password
- Log Out
- EN
- EN - English
- CN - 中文
- Protocols
- Articles and Issues
- For Authors
- About
- Become a Reviewer
- EN - English
- CN - 中文
- Home
- Protocols
- Articles and Issues
- For Authors
- About
- Become a Reviewer
Culture and Detection of Mycobacterium tuberculosis (MTB) and Mycobacterium bovis (BCG)
Published: Vol 2, Iss 1, Jan 20, 2012 DOI: 10.21769/BioProtoc.49 Views: 36962

Protocol Collections
Comprehensive collections of detailed, peer-reviewed protocols focusing on specific topics
Related protocols
Microbial Mutagenicity Assay: Ames Test
Urvashi Vijay [...] Pradeep Bhatnagar
Mar 20, 2018 36209 Views

Isolation of Commensal Escherichia coli Strains from Feces of Healthy Laboratory Mice or Rats
Tingting Ju and Benjamin P. Willing
Mar 20, 2018 10913 Views

Detachment Procedure of Bacteria from Atmospheric Particles for Flow-cytometry Counting
Carolina M. Araya [...] Isabel Reche
Jun 20, 2019 5592 Views
Abstract
Mycobacterium tuberculosis (MTB) is the bacterial pathogen responsible for tuberculosis, a human pulmonary infectious disease. Mycobacterium bovis (BCG) is the causative agent of tuberculosis in cattle, and is often used as the vaccine stain in humans. Specific recipes and methods for culture of MTB and BCG are described in this protocol.
Keywords: Mycobacterium tuberculosisMaterials and Reagents
- Middlebrook 7H9 broth base powder (Sigma-Aldrich, catalog number: M0178 )
- Middlebrook 7H11 agar base powder (Sigma-Aldrich, catalog number: M0428 )
- Middlebrook OADC growth supplement (Sigma-Aldrich, catalog number: M0678 )
- BD TB quick stain kit (BD Biosciences, catalog number: 212522 )
- General chemicals (Sigma-Aldrich)
- ADNaCl (see Recipes)
- 7H9 liquid medium (see Recipes)
- 7H11 agar plates (see Recipes)
Equipment
- T75 tissue culture flasks (Sigma-Aldrich, catalog number: Z707546 )
- Standard glass microscope slides
- Light microscope
- Bunsen burner or fixed flame source
- Standard sterile petri dishes
Procedure
- Culture
- Preparing 7H9 liquid medium
- Day 1: Resuspend 1 frozen vial of 1 ml (450 million) MTB or BCG (stored in 15% glycerol and 85% 7H9 liquid medium) in 20 ml 7H9 liquid medium in a T75 flask.
- Culture horizontally in an incubator humidified at 37 °C without CO2 for 5 - 14 days.
- Measure the OD600 every 5 days, till OD600 reaches 2.0.
- Viable MTB/BCG colonies can be counted by plating bacterial suspensions at different dilutions on Middlebrook 7H11 agar plates supplemented with OADC, and then counting colonies after two weeks.
- Harvest the bacteria through spin-down at room temperature, 3,000 x g for 7 min.
- Preparing 7H9 liquid medium
- Detection: Ziehl-Neelsen acid-fast staining detection procedure
- Pipet 10 μl MTB/BCG culture on a glass microscope slide and heat on top of a Bunsen flame until it is completely dry to fix the bacteria.
- Flood the slide with carbol fuchsin stain (BD kit reagent A).
- Heat the slide gently until it steams (5 min).
- Pour off the carbol fuchsin.
- Wash slide thoroughly with tap water (5 min).
- Decolorize with acid-alcohol (5 min).
- Wash slide thoroughly with tap water (5 min).
- Flood slide with methylene blue (BD kit reagent B) counterstain (1 min).
- Wash with tap water.
- Blot excess water and dry in hand over Bunsen flame.
- The slide is now ready to observe under a standard light microscope.
- Pipet 10 μl MTB/BCG culture on a glass microscope slide and heat on top of a Bunsen flame until it is completely dry to fix the bacteria.
Recipes
- ADNaCl
15 g BSA
6 g Dextrose
2.55 g NaCl
Dissolve in 300 ml ddH2O
Note: BSA will take some time to go into solution. Filter to sterilize the supplement and store covered in foil at 4 °C. Do not store for more than one month. - 7H9 liquid medium
Dissolve 4.7 g of 7H9 powder in 900 ml dH2O
Add 2 ml glycerol and mix well
Autoclave and let cool completely
Store medium at room temperature in the dark
Note: Do not use medium that has been stored for longer than a month.
Right before use, add 2.5 ml 20% Tween 80 (filter sterilized) and 10% ADNaCl supplement. At this point the media can be filter sterilized or used directly. Media to which the supplement and Tween have been added should be stored at 4 °C and used within a few weeks.
- 7H11 agar plates
Dissolve 21 g of 7H11 powder in 900 ml dH2O
Add 5 ml glycerol and swirl to obtain a smooth suspension
Note: Boil if necessary to completely dissolve the powder.
Autoclave at 121 °C for 15 min
Add 100 ml Middlebrook OADC Enrichment and 2.5 ml 20% Tween 80 (filter sterilized) to the medium when cooled to 50-55 °C
Mix well and pour to make agar plates
Acknowledgments
This work was funded by 5050 project by Hangzhou Hi-Tech District, Funding for Oversea Returnee by Hangzhou City, ZJ1000 project by Zhejiang Province. This protocol was developed in the Cohen Lab, Department of Genetics, Stanford University, CA, USA [Chen et al. (unpublished)].
References
- Cole, S. T., Brosch, R., Parkhill, J., Garnier, T., Churcher, C., Harris, D., Gordon, S. V., Eiglmeier, K., Gas, S., Barry, C. E., 3rd, Tekaia, F., Badcock, K., Basham, D., Brown, D., Chillingworth, T., Connor, R., Davies, R., Devlin, K., Feltwell, T., Gentles, S., Hamlin, N., Holroyd, S., Hornsby, T., Jagels, K., Krogh, A., McLean, J., Moule, S., Murphy, L., Oliver, K., Osborne, J., Quail, M. A., Rajandream, M. A., Rogers, J., Rutter, S., Seeger, K., Skelton, J., Squares, R., Squares, S., Sulston, J. E., Taylor, K., Whitehead, S. and Barrell, B. G. (1998). Deciphering the biology of Mycobacterium tuberculosis from the complete genome sequence. Nature 393(6685): 537-544.
- Frieden, T. R., Sterling, T. R., Munsiff, S. S., Watt, C. J. and Dye, C. (2003). Tuberculosis. Lancet 362(9387): 887-899.
Article Information
Copyright
© 2012 The Authors; exclusive licensee Bio-protocol LLC.
How to cite
Chen, R. (2012). Culture and Detection of Mycobacterium tuberculosis (MTB) and Mycobacterium bovis (BCG). Bio-protocol 2(1): e49. DOI: 10.21769/BioProtoc.49.
Category
Microbiology > Microbial cell biology > Cell isolation and culture
Cell Biology > Cell isolation and culture > Cell growth
Cell Biology > Cell staining > Other compound
Do you have any questions about this protocol?
Post your question to gather feedback from the community. We will also invite the authors of this article to respond.
Share
Bluesky
X
Copy link








